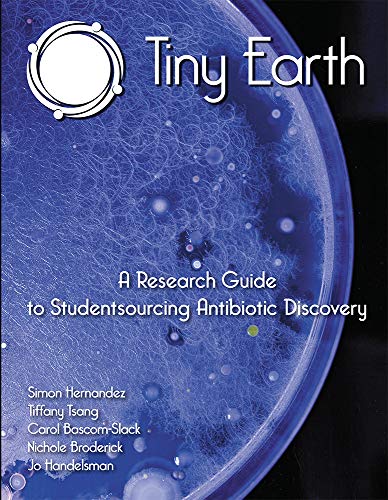
Tiny Earth - A Research Guide to Studentsourcing Antibiotic Discovery (Print plus e-Book access)

Tiny Earth - A Research Guide to Studentsourcing Antibiotic Discovery (Print plus e-Book access)
Tiny Earth - A Research Guide to Studentsourcing Antibiotic Discovery (Print plus e-Book access)
Regular price
Checking stock...
Regular price
Checking stock...
World of Books
At World of Books, you’ll find millions of preloved reads at great prices, from bestsellers to hidden gems. Every book you buy saves money and helps reduce waste, so you can read more for less while giving stories a second life.
The feel-good place to buy books
- Free US shipping over $15
- Buying preloved emits 41% less CO2 than new
- Millions of affordable books
- Give your books a new home - sell them back to us!
| SKU | Unavailable |
| ISBN 13 | 9781593994938 |
| ISBN 10 | 1593994931 |
| Title | Tiny Earth - A Research Guide to Studentsourcing Antibiotic Discovery (Print plus e-Book access) |
| Author | Et Al |
| Condition | Unavailable |
| Binding Type | Paperback |
| Publisher | XanEdu Publishing Inc |
| Year published | 2018-10-15 |
| Number of pages | 203 |
| Cover note | Book picture is for illustrative purposes only, actual binding, cover or edition may vary. |
| Note | Unavailable |